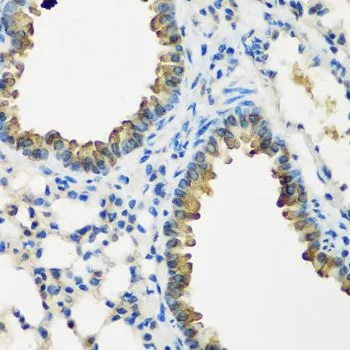

WB analysis of various sample lysates using GTX33136 CYP2F1 antibody. Dilution : 1:1000 Loading : 25microg per lane
CYP2F1 antibody
GTX33136
ApplicationsWestern Blot, ImmunoHistoChemistry, ImmunoHistoChemistry Paraffin
Product group Antibodies
ReactivityHuman, Mouse, Rat
TargetCYP2F1
Overview
- SupplierGeneTex
- Product NameCYP2F1 antibody
- Delivery Days Customer9
- Application Supplier NoteWB: 1:500 - 1:2000. IHC-P: 1:50 - 1:200. *Optimal dilutions/concentrations should be determined by the researcher.Not tested in other applications.
- ApplicationsWestern Blot, ImmunoHistoChemistry, ImmunoHistoChemistry Paraffin
- CertificationResearch Use Only
- ClonalityPolyclonal
- ConjugateUnconjugated
- Gene ID1572
- Target nameCYP2F1
- Target descriptioncytochrome P450 family 2 subfamily F member 1
- Target synonymsC2F1, CYP2F, CYPIIF1, cytochrome P450 2F1, cytochrome P450, family 2, subfamily F, polypeptide 1, cytochrome P450, subfamily IIF, polypeptide 1, flavoprotein-linked monooxygenase, microsomal monooxygenase, xenobiotic monooxygenase
- HostRabbit
- IsotypeIgG
- Protein IDP24903
- Protein NameCytochrome P450 2F1
- Scientific DescriptionThis gene encodes a member of the cytochrome P450 superfamily of enzymes. The cytochrome P450 proteins are monooxygenases which catalyze many reactions involved in drug metabolism and synthesis of cholesterol, steroids and other lipids. This protein localizes to the endoplasmic reticulum and is known to dehydrogenate 3-methylindole, an endogenous toxin derived from the fermentation of tryptophan, as well as xenobiotic substrates such as naphthalene and ethoxycoumarin. This gene is part of a large cluster of cytochrome P450 genes from the CYP2A, CYP2B and CYP2F subfamilies on chromosome 19q. [provided by RefSeq, Jul 2008]
- ReactivityHuman, Mouse, Rat
- Storage Instruction-20°C or -80°C,2°C to 8°C
- UNSPSC12352203